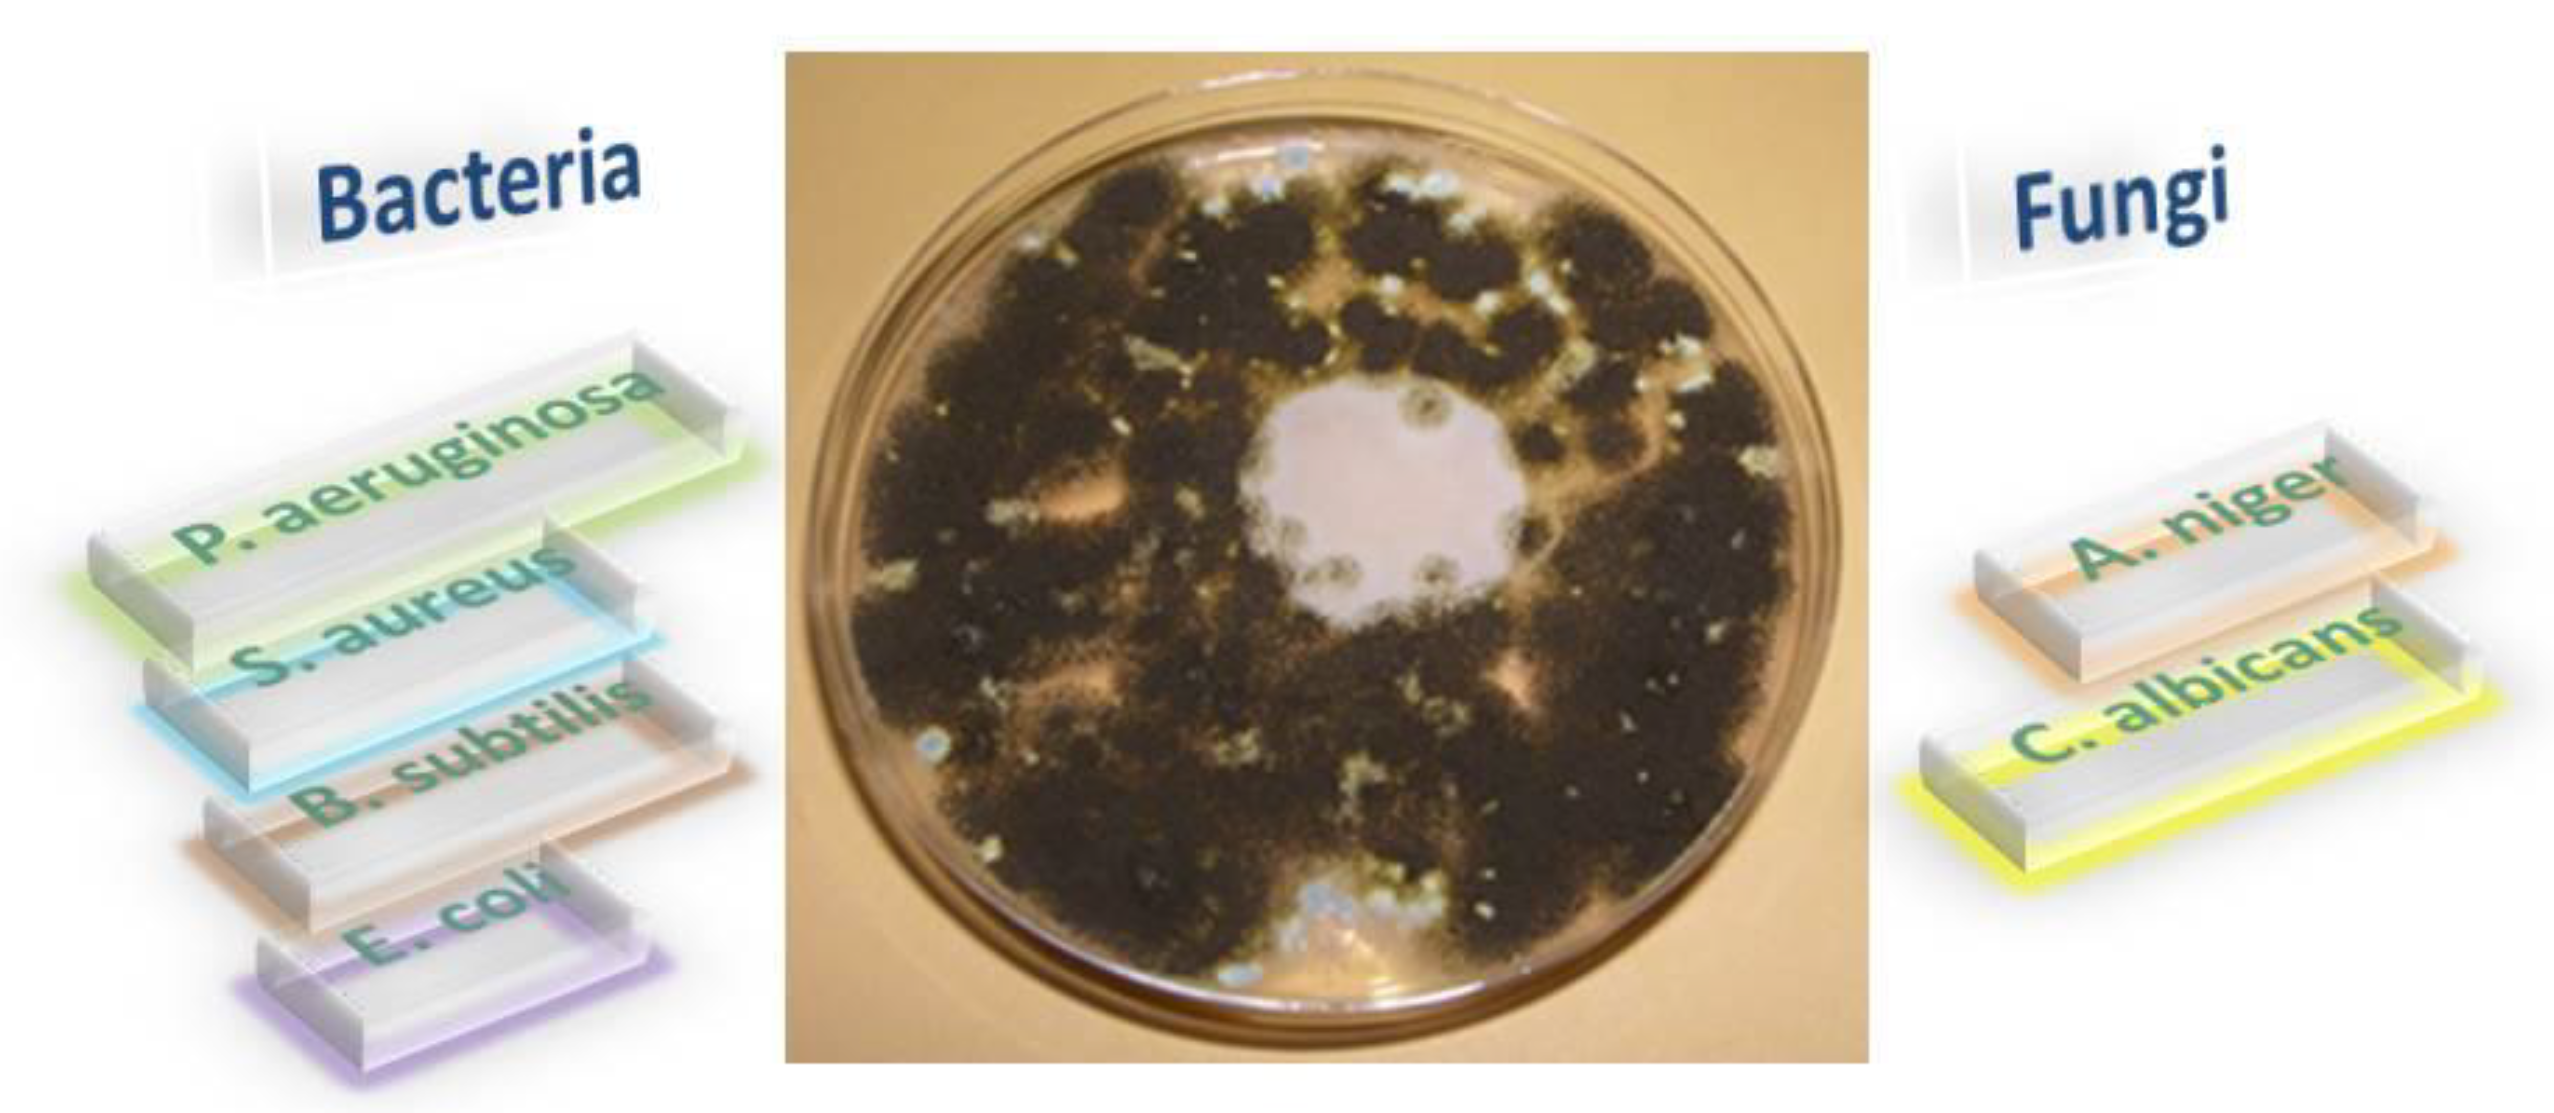
Crystals 12 01436 g003

Advanced and Biomedical Applications of Schiff-Base Ligands and Their Metal Complexes: A Review
Abstract
1. Introduction
2. Some Aspects of the Biological Significance of Schiff-Base Complexes
2.1. Antimicrobial Activity (Antibacterial and Antifungal)
2.2. Antioxidant Activity
2.3. Redox Activity of the Studied Schiff-Bases and Their Complexes with Different Metals
3. Schiff-Base Complexes as Catalysts
4. Conclusions
Author Contributions
Funding
Institutional Review Board Statement
Informed Consent Statement
Data Availability Statement
Conflicts of Interest
References
- Mohamed, G.G. Synthesis, characterization and biological activity of bis(phenylimine) Schiff base ligands and their metal complexes. Spectrochim. Acta A 2006, 64, 188. [Google Scholar] [CrossRef]
- Tofazzal, M.; Tarafder, H.; Ali, M.A.; Saravanan, N.; Weng, W.Y.; Kumar, S.; Tsafe, N.U.; Crouse, K.A. Coordination chemistry and biological activity of two tridentate ONS and NNS Schiff bases derived from S-benzyldithiocarbazate. Trans. Met. Chem. 2000, 25, 295–298. [Google Scholar]
- Chandra, S.; Jain, D.; Sharma, A.K.; Sharma, P. Coordination Modes of a Schiff Base Pentadentate Derivative of 4-Aminoantipyrine with Cobalt (II), Nickel (II) and Copper (II) Metal Ions: Synthesis, Spectroscopic and Antimicrobial Studies. Molecules 2009, 14, 174–190. [Google Scholar] [CrossRef]
- Golcu, A.; Tumer, M.; Demirelli, H.; Wheatley, R.A. Cd (II) and Cu (II) complexes of polydentate Schiff base ligands: Synthesis, characterization, properties and biological activity. Inorg. Chim. Acta 2005, 358, 1785–1797. [Google Scholar] [CrossRef]
- Sinha, D.; Tiwari, A.K.; Singh, S.; Shukla, G.; Mishra, P.; Chandra, H.; Mishra, A.K. Synthesis, characterization and biological activity of Schiff base analogues of indole-3-carboxaldehyde. Eur. J. Med. Chem. 2008, 43, 160–165. [Google Scholar] [CrossRef] [PubMed]
- Phatak, P.; Jolly, V.S.; Sharma, K.P. Synthesis and Biological Activities of Some New Substituted Arylazo Schiff Bases. Orient. J. Chem. 2000, 16, 493. [Google Scholar]
- Ansary, E.; Soliman, A.L.; Sherif, A.A.; Ezzat, J.A. Preparation and thermal study of new complexes of salicylidene-2-aminothiophenol Schiff bases. Synth. React. Inorg. Met.-Org. Chem. 2002, 32, 1301–1318. [Google Scholar] [CrossRef]
- Tuncel, M.; Serin, S. Synthesis and Characterization of Copper(II), Nickel(II), and Cobalt(II) Chelates with Tridentate Schiff Base Ligands Derived from 4-Amino-5-hydroxynaphthalene-2,-7-disulfonic Acid. Synth. React. Inorg. Met.-Org. Chem. 2003, 33, 985–998. [Google Scholar] [CrossRef]
- Çelik, C.; Tumer, M.; Serin, S. Complexes of tetradentate Schiff base ligands with divalent transition metals. Synth. React. Inorg. Met.-Org. Chem. 2002, 32, 1839–1854. [Google Scholar] [CrossRef]
- Temel, H.; Ilhan, S.; Sekerci, M.; Ziyadanoullar, R. The synthesis and spectral characterization of new Cu(II), Ni(II), Co(III), and Zn(II) complexes with Schiff Base. Spectrosc. Lett. 2002, 35, 219–228. [Google Scholar] [CrossRef]
- Karmakar, M.; Chattopadhyay, S. A comprehensive overview of the orientation of tetradentate N2O2 donor Schiff base ligands in octahedral complexes of trivalent 3d metals. J. Molec. Struct. 2019, 1186, 155–186. [Google Scholar] [CrossRef]
- Nguyen, Q.T.; Thi, P.N.P.; Nguyen, V.T. Synthesis, Characterization, and In Vitro Cytotoxicity of Unsymmetrical Tetradentate Schiff Base Cu(II) and Fe(III) Complexes. Bioinorg. Chem. Appl. 2021, 6696344. [Google Scholar] [CrossRef]
- Freire, C.; Nunes, M.; Pereira, C.; Fernandes, D.M.; Peixoto, A.F.; Rocha, M. Metallo(salen) complexes as versatile building blocks for the fabrication of molecular materials and devices with tuned properties. Coord. Chem. Rev. 2019, 394, 104–134. [Google Scholar] [CrossRef]
- Erxleben, A. Transition metal salen complexes in bioinorganic and medicinal chemistry. Inorg. Chim. Acta 2018, 472, 40–57. [Google Scholar] [CrossRef]
- Liu, X.; Manzur, C.; Novoa, N.; Celedón, S.; Carrillo, D.; Hamon, J.R. Multidentate unsymmetrically-substituted Schiff bases and their metal complexes: Synthesis, functional materials properties, and applications to catalysis. Coord. Chem. Rev. 2018, 357, 144–172. [Google Scholar] [CrossRef]
- Pessoa, J.C.; Correia, I. Salan vs. salen metal complexes in catalysis and medicinal applications: Virtues and pitfalls. Coord. Chem. Rev. 2019, 388, 227–247. [Google Scholar] [CrossRef]
- Yuan, G.; Jiang, H.; Zhang, L.; Liu, Y.; Cui, Y. Metallosalen-based crystalline porous materials: Synthesis and property. Coord. Chem. Rev. 2019, 378, 483–499. [Google Scholar] [CrossRef]
- Shimazaki, Y. Oxidation Chemistry of Metal(II) Salen-Type Complexes. In Electrochemistry; Khalid, M.A.A., Ed.; InTech: Rijeka, Croatia, 2013; Chapter 3; pp. 51–70. [Google Scholar]
- Ali, A.; Kamra, M.; Roy, S.; Muniyappa, K.; Bhattacharya, S. Novel Oligopyrrole Carboxamide based Nickel(II) and Palladium(II) Salens, Their Targeting of Human G-Quadruplex DNA and Selective Cancer Cell Toxicity. Chem. Asian J. 2016, 11, 2542–2554. [Google Scholar] [CrossRef]
- Saini, A.K.; Kumari, P.; Sharma, V.; Mathur, P.; Mobin, S.M. Varying structural motifs in the salen based metal complexes of Co(II), Ni(II) and Cu(II): Synthesis, crystal structures, molecular dynamics and biological activities. Dalton Trans. 2016, 45, 19096–19108. [Google Scholar] [CrossRef]
- Consiglio, G.; Oliveri, I.P.; Failla, S.; Di Bella, S. On the Aggregation and Sensing Properties of Zinc(II) Schiff-Base Complexes of Salen-Type Ligands. Molecules 2019, 25, 2514. [Google Scholar] [CrossRef]
- Matozzo, P.; Colombo, A.; Dragonetti, C.; Righetto, S.; Roberto, D.; Biagini, P.; Fantacci, S.; Marinotto, D. Chiral Bis(salicylaldiminato)zinc(II) Complex with Second-Order Nonlinear Optical and Luminescent Properties in Solution. Inorganics 2020, 8, 25. [Google Scholar] [CrossRef]
- Sagar Babu, S.V.; Krishna Rao, K.; Ill Lee, Y. Synthesis, characterization, luminescence and DNA binding properties of Ln (III)-Schiff base family. J. Chil. Chem. Soc. 2017, 62, 3447–3453. [Google Scholar] [CrossRef]
- Leoni, L.; Cort, A.D. The Supramolecular Attitude of Metal–Salophen and Metal–Salen Complexes. Inorganics 2018, 6, 42. [Google Scholar] [CrossRef]
- Novoa, N.; Manzur, C.; Roisnel, T.; Kahlal, S.; Saillard, J.Y.; Carrilo, D.; Hamon, J.R. Nickel(II)-Based Building Blocks with Schiff Base Derivatives: Experimental Insights and DFT Calculations. Molecules 2021, 26, 5316. [Google Scholar] [CrossRef]
- Vigato, P.A.; Tamburini, S. The challenge of cyclic and acyclic schiff bases and related derivatives. Coord. Chem. Rev. 2004, 248, 1717–2128. [Google Scholar] [CrossRef]
- Biswas, C.; Drew, M.G.B.; Figuerola, V.; Gomez-Coca, S.; Ruiz, E.; Tangoulis, V.; Ghosh, A. Magnetic coupling in trinuclear partial cubane copper(II) complexes with a hydroxo bridging core and peripheral phenoxo bridges from NNO donor Schiff base ligands. Inorg. Chim. Acta 2010, 363, 846–854. [Google Scholar] [CrossRef]
- Ding, C.X.; Ni, J.; Yang, Y.H.; Ng, S.W.; Wang, B.W.; Shu, Y.X. Mono-, Tetra- and octanuclear transition metal complexes of in situ generated schiff baseligands containing up to 12 coordinating atoms: Syntheses, structures and magnetism. Cryst. Eng. Comm. 2012, 21, 7312–7319. [Google Scholar] [CrossRef]
- Wang, J.L.; Liu, B.; Yang, B.S. A novel class of oligomeric and polymeric d10 metal complexes of asymmetrical N-heterocyclic ligand with strong π-stacking and hydrogen bonding: Syntheses, structures, and photoluminescence. Cryst. Eng. Comm. 2011, 13, 7086–7097. [Google Scholar]
- Elmali, A.; Zeyrek, C.T.; Elerman, Y. Crystal structure, magnetic properties and molecular orbital calculations of a binuclear copper(II) complex bridged by an alkoxo-oxygen atom and an acetate ion. J. Mol. Struct. 2004, 693, 225–234. [Google Scholar] [CrossRef]
- Xu, H.B.; Wang, B.W.; Pan, F.; Wang, Z.M.; Gao, S. Stringing Oxo-Centered Trinuclear [MnIII3O] Units into Single-Chain Magnets with Formate or Azide Linkers. Angew. Chem. Int. Ed. 2007, 119, 7532–7536. [Google Scholar] [CrossRef]
- Zheng, W.X.; Wei, Y.Q.; Tian, C.B.; Xiao, X.Y.; Wu, K.C. Spontaneous resolution of a homochiral helix built from a tetra-nuclear nickel cluster. Cryst. Eng. Comm. 2012, 14, 3347–3350. [Google Scholar] [CrossRef]
- Erxleben, A.; Hermann, J. Di- and poly-nuclear zinc(II) Schiff base complexes: Synthesis, structural studies and reaction with an α-amino acid ester. J. Chem. Soc. Dalton Trans. 2000, 4, 569–575. [Google Scholar] [CrossRef]
- Guo, J.; Ma, J.F.; Liu, B.; Kan, W.Q.; Yang, J. A Series of 2D and 3D Metal–Organic Frameworks Based on a Flexible Tetrakis(4-pyridyloxymethylene)methane Ligand and Polycarboxylates: Syntheses, Structures, and Photoluminescent Properties. Cryst. Growth Des. 2011, 11, 3609–3621. [Google Scholar] [CrossRef]
- Kumar, S.; Dhar, D.N.; Saxsena, P.N. Applications of metal complexes of Schiff bases-A review. J. Scient. Ind. Res. 2009, 68, 181–187. [Google Scholar]
- Habib, H.A.; Hernández, B.G.; Shandi, K.A.; Sanchiz, J.; Janiak, C. Iron, copper and zinc ammonium-1-hydroxyalkylidene-diphosphonates with zero-, one- and two-dimensional covalent metal–ligand structures extended into three-dimensional supramolecular networks by charge-assisted hydrogen-bonding. Polyhedron 2010, 29, 2537–2545. [Google Scholar] [CrossRef]
- Li, Y.; Wu, Y.; Zhao, J.; Yang, P. DNA-binding and cleavage studies of novel binuclear copper(II) complex with 1,10-dimethyl-2,20-biimidazole ligand. J. Inorg. Biochem. 2007, 101, 283–290. [Google Scholar] [CrossRef]
- Lv, J.; Liu, T.; Cai, S.; Wang, X.; Liu, L.; Wang, Y. Synthesis, structure and biological activity of cobalt(II) and copper(II) complexes of valine-derived schiff bases. J. Inorg. Biochem. 2006, 100, 1888–1896. [Google Scholar] [CrossRef]
- Costamagna, J.; Ferraudi, G.; Matsuhiro, B.; Campos-Vallette, M.; Canales, J.; Villagran, M.; Vargas, J.; Aguirre, M.J. Complexes of macrocycles with pendant arms as models for biological molecules. Coord. Chem. Rev. 2000, 196, 125–164. [Google Scholar] [CrossRef]
- Dong, Y.B.; Zhang, A.K.; Ma, J.P.; Huang, R.Q. Novel One- and Two-Dimensional Ag(I) Networks Generated from Double Schiff Base Ligands with Disubstituted Quinoxaline Diazenes as the Terminal Binding Sites. Cryst. Growth Des. 2005, 5, 1857–1866. [Google Scholar] [CrossRef]
- Afsan, Z.; Roisnel, T.; Tabassum, S.; Arjmand, F. Structure elucidation {spectroscopic, single crystal X-ray diffraction and computational DFT studies} of new tailored benzenesulfonamide derived Schiff base copper(II) intercalating complexes: Comprehensive biological profile {DNA binding, pBR322 DNA cleavage, Topo I inhibition and cytotoxic activity}. Bioorg. Chem. 2020, 94, 103427. [Google Scholar]
- Kargar, H.; Behjatmanesh-Ardakani, R.; Torabi, V.; Sarvian, A.; Kazemi, Z.; Chavoshpour-Natanzi, Z.; Mirkhani, V.; Sahraei, A.; Tahir, M.N.; Ashfaq, M.; et al. Novel copper(II) and zinc(II) complexes of halogenated bidentate N, O-donor Schiff base ligands: Synthesis, characterization, crystal structures, DNA binding, molecular docking, DFT and TD-DFT computational studies. Inorg. Chim. Acta 2021, 514, 120004. [Google Scholar] [CrossRef]
- Abu-Dief, A.M.; Mohamed, I.M.A. A review on versatile applications of transition metal complexes incorporating Schiff bases. Beni Suef. Univ. J. Basic Appl. Sci. 2015, 4, 119–133. [Google Scholar] [CrossRef] [PubMed]
- More, M.S.; Joshi, P.G.; Mishra, Y.K.; Khanna, P.K. Metal complexes driven from Schiff bases and semicarbazones for biomedical and allied applications: A review. Mater. Today Chem. 2019, 14, 100195. [Google Scholar] [CrossRef] [PubMed]
- Utreja, D.; Vibha, B.S.P.; Singh, S.; Kaur, M. Schiff Bases and their Metal Complexes as Anti-Cancer Agents: A Review. CBC 2015, 11, 215–230. [Google Scholar] [CrossRef]
- Abd-Elzaher, M.M.; Labib, A.A.; Mousa, H.A.; Moustafa, S.A.; Ali, M.M.; El-Rashedy, A.A. Synthesis, anticancer activity and molecular docking study of Schiff base complexes containing thiazole moiety. Beni-Suef Univ. J. Basic Appl. Sci. 2016, 5, 85–96. [Google Scholar] [CrossRef]
- Ren, S.; Wang, R.; Komatsu, K.; Bonaz-Krause, P.; Zyrianov, Y.; Mckenna, C.E.; Csipke, C.; Tokes, Z.A.; Lien, E.J. Synthesis, biological evaluation, and quantitative structure-activity relationship analysis of new Schiff bases of hydroxysemicarbazide as potential antitumor agents. J. Med. Chem. 2002, 45, 410–419. [Google Scholar] [CrossRef]
- Venkatachalam, G.; Ramesh, R. Ruthenium(III) bis-bidentate Schiff base complexes mediated transfer hydrogenation of imines. Inorg. Chem. Commun. 2006, 9, 703–707. [Google Scholar]
- Kannan, S.; Ramesh, R.; Liu, Y. Ruthenium(III) mediated C–H activation of azonaphthol: Synthesis, structural characterization and transfer hydrogenation of ketones. J. Organomet. Chem. 2007, 692, 3380–3391. [Google Scholar] [CrossRef]
- Zoubi, W.A.; Ko, Y.G. Schiff base complexes and their versatile applications as catalysts in oxidation of organic compounds: Part I. Appl. Organomet. Chem. 2016, 31, e3574. [Google Scholar] [CrossRef]
- Ghanghas, P.; Choudhary, A.; Kumar, D.; Poonia, K. Coordination metal complexes with Schiff bases: Useful pharmacophores with comprehensive biological applications. Inorg. Chem. Commun. 2021, 130, 108710. [Google Scholar] [CrossRef]
- Chkirate, K.; Karrouchi, K.; Chakchak, H.; Mague, J.T.; Radi, S.; Adarsh, N.N.; Li, W.; Talbaoui, A.; Essassia, E.M.; Garcia, Y. Coordination complexes constructed from pyrazole–acetamide and pyrazole–quinoxaline: Effect of hydrogen bonding on the self-assembly process and antibacterial activity. RSC Adv. 2022, 12, 5324. [Google Scholar] [CrossRef]
- Turecka, K.; Chylewska, A.; Rychlowski, M.; Zakrzewska, J.; Waleron, K. Antibacterial Activity of Co(III) Complexes with Diamine Chelate Ligands against a Broad Spectrum of Bacteria with a DNA Interaction Mechanism. Pharmaceutics 2021, 13, 946. [Google Scholar] [CrossRef] [PubMed]
- Salishcheva, O.V.; Prosekov, A.Y. Antimicrobial activity of mono- and polynuclear platinum and palladium complexes. Foods Raw Mater. 2020, 8, 298–311. [Google Scholar] [CrossRef]
- Ngoepe, M.P.; Clayton, H.S. Metal Complexes as DNA Synthesis and/or Repair Inhibitors: Anticancer and Antimicrobial Agents. Pharm. Fronts 2021, 3, e164–e182. [Google Scholar] [CrossRef]
- Claudel, M.; Schwarte, J.V.; Fromm, K.M. New Antimicrobial Strategies Based on Metal Complexes. Chemistry 2020, 2, 849–899. [Google Scholar] [CrossRef]
- Kumar, M.; Kumar, G.; Masram, D.T. Copper(II) complexes containing Enoxacin and heterocyclic ligands: Synthesis, crystal structures and their biological Perspectives. New J. Chem. 2020, 44, 8595–8613. [Google Scholar] [CrossRef]
- Soroceanu, A.; Cazacu, M.; Shova, S.; Turta, C.; Kozısek, J.; Gall, M.; Breza, M.; Rapta, P.; Mac Leod, T.C.O.; Pombeiro, J.L.; et al. Copper (II) complexes with Schiff bases containing a disiloxane unit: Synthesis, structure, bonding features and catalytic activity for aerobic oxidation of benzyl alcohol. Eur. J. Inorg. Chem. 2013, 9, 1458–1474. [Google Scholar] [CrossRef]
- Zaltariov, M.F.; Cazacu, M.; Vornicu, N.; Shova, S.; Racles, C.; Balan, M.; Turta, C. A new diamine containing disiloxane moiety and some derived Schiff bases: Synthesis, structural characterisation and antimicrobial activity. Supramol. Chem. 2013, 25, 490–502. [Google Scholar] [CrossRef]
- Cazacu, M.; Shova, S.; Soroceanu, A.; Machata, P.; Bucinsky, L.; Breza, M.; Rapta, P.; Telser, J.; Krzystek, J.; Arion, V.B. Charge and Spin States in Schiff Base Metal Complexes with a Disiloxane Unit Exhibiting a Strong Noninnocent Ligand Character: Synthesis, Structure, Spectroelectrochemistry, and Theoretical Calculations. Inorg. Chem. 2015, 54, 5691–5706. [Google Scholar] [CrossRef] [PubMed]
- Vlad, A.; Zaltariov, M.F.; Shova, S.; Cazacu, M.; Avadanei, M.; Soroceanu, A.; Samoila, P. New Zn (II) and Cu (II) complexes with in situ generated N2O2 siloxane Schiff base ligands. Polyhedron 2016, 115, 76–85. [Google Scholar] [CrossRef]
- Vlad, A.; Avadanei, M.; Shova, S.; Cazacu, M.; Zaltariov, M.F. Synthesis, structural characterization and properties of some novel siloxane-based bis-Schiff base copper (II), nickel (II) and manganese (II) complexes. Polyhedron 2018, 146, 129–135. [Google Scholar] [CrossRef]
- Damoc, M.; Stoica, A.C.; Macsim, A.M.; Dascalu, M.; Zaltariov, M.F.; Cazacu, M. Salen-type Schiff bases spaced by the highly flexible and hydrophobic tetramethyldisiloxane motif. Some synthetic, structural and behavioral particularities. J. Molec. Liq. 2020, 316, 113852. [Google Scholar] [CrossRef]
- Racles, C.; Zaltariov, M.F.; Damoc, M.; Macsim, A.M.; Iacob, M.; Sacarescu, L. Three Reactions, One Catalyst: A Multi-Purpose Platinum (IV) Complex and its Silica-Supported Homologue for Environmentally Friendly Processes. Appl. Organomet. Chem. 2020, 34, e5422. [Google Scholar] [CrossRef]
- Kargar, H.; Fallah-Mehrjardi, M.; Behjatmanesh-Ardakani, R.; Rudbari, H.A.; Ardakani, A.A.; Sedighi-Khavidak, S.; Munawarf, K.S.; Ashfaq, M.; Tahir, M.N. Synthesis, spectral characterization, crystal structures, biological activities, theoretical calculations and substitution effect of salicylidene ligand on the nature of mono and dinuclear Zn(II) Schiff base complexes. Polyhedron 2022, 213, 115636. [Google Scholar] [CrossRef]
- Nath, B.D.; Islam, M.; Karim, R.; Rahman, S.; Shaikh, A.A.; Georghiou, P.E.; Menelaou, M. Recent Progress in Metal-Incorporated Acyclic Schiff-Base Derivatives: Biological Aspects. ChemistrySelect 2022, 7, e20210429. [Google Scholar] [CrossRef]
- Abid, K.K.; Al-Bayati, R.H.; Faeq, A.A. Transition metal complexes of new N-amino quinolone derivative; synthesis, characterization, thermal study and antimicrobial properties. J. Am. Chem. Soc. 2016, 6, 29–35. [Google Scholar]
- Abu-Dief, M.; Nassr, L.A.E. Tailoring, physicochemical characterization, antibacterial and DNA binding mode studies of Cu(II) Schiff bases amino acid bioactive agents incorporating 5-bromo- 2-hydroxybenzaldehyde. J. Iran. Chem. Soc. 2015, 12, 943–955. [Google Scholar] [CrossRef]
- Abdel-Rahman, L.H.; Abu-Dief, A.M.; Hashem, N.A.; Seleem, A.A. Recent advances in synthesis, characterization and biological activity of nano sized Schiff base amino acid M(II) complexes. Int. J. Nanomater. Chem. 2015, 1, 79–95. [Google Scholar]
- Yousif, E.; Majeed, A.; Al-Sammarrae, K.; Salih, N.; Salimon, J.; Abdullah, B. Metal complexes of Schiff base: Preparation, characterization and antibacterial activity. Arab. J. Chem. 2017, 10, 1639–1644. [Google Scholar] [CrossRef]
- Horozic, E.; Suljagic, J.; Suljkanovic, M. Synthesis, characterization, antioxidant and antimicrobial activity of Copper (II) complex with Schiff base derived from 2,2-dihydroxyindane-1, 3-dione and Tryptophan. Am. J. Org. Chem. 2019, 9, 9–13. [Google Scholar]
- Abu-Yamin, A.A.; Abduh, M.S.; Saghir, S.A.M.; Al-Gabri, N. Synthesis, Characterization and Biological Activities of New Schiff Base Compound and Its Lanthanide Complexes. Pharmaceuticals 2022, 15, 454. [Google Scholar] [CrossRef]
- Liang, J.; Sun, D.; Yang, Y.; Li, M.; Li, H.; Chen, L. Discovery of metal-based complexes as promising antimicrobial agents. Eur. J. Med. Chem. 2021, 224, 113696. [Google Scholar] [CrossRef]
- Parveen, S.; Arjmand, F.; Zhang, Q.; Ahmad, M.; Khan, A.; Toupet, L. Molecular docking, DFT and antimicrobial studies of Cu(II) complex as topoisomerase I inhibitor. J. Biomol. Struct. Dyn. 2020, 39, 2092–2105. [Google Scholar] [CrossRef]
- Lobana, T.S.; Kaushal, M.; Bala, R.; Nim, L.; Paul, K.; Arora, D.S.; Bhatia, A.; Arora, S.; Jasinski, J.P. Di-2-pyridylketone-N(1)-substituted thiosemicarbazone derivatives of copper(II): Biosafe antimicrobial potential and high anticancer activity against immortalized L6 rat skeletal muscle cells. J. Inorg. Biochem. 2020, 212, 111205. [Google Scholar] [CrossRef]
- Soroceanu, A.; Vacareanu, L.; Vornicu, N.; Cazacu, M.; Rudic, V.; Croitori, T. Assessment of some application potentials for copper complexes of the ligands containing siloxane moiety: Antimicrobial, antifungal, antioxidant and redox activity. Inorg. Chim. Acta 2016, 442, 119–123. [Google Scholar] [CrossRef]
- Zaltariov, M.F.; Vlad, A.; Cazacu, M.; Avadanei, M.; Vornicu, N.; Balan, M.; Shova, S. Silicon-containing bis-azomethines: Synthesis, structural characterization, evaluation of the photophysical properties and biological activity. Spectrochim. Acta A Mol. Biomol. Spectrosc. 2015, 138, 38–48. [Google Scholar] [CrossRef]
- Zaltariov, M.F.; Cazacu, M.; Avadanei, M.; Shova, S.; Balan, M.; Vornicu, N.; Vlad, A.; Dobrov, A.; Varganici, C.D. Synthesis, characterization and antimicrobial activity of new Cu(II) and Zn(II) complexes with Schiff bases derived from trimethylsilyl-propyl-p-aminobenzoate. Polyhedron 2015, 100, 121–131. [Google Scholar] [CrossRef]
- Halawa, A.H.; El-Gilil, S.M.A.; Bedair, A.H.; Shaaban, M.; Frese, M.; Sewald, N.; Eliwa, E.M.; El-Agrody, A.M. Synthesis, biological activity and molecular modeling study of new Schiff bases incorporated with indole moiety. Z. Naturforsch. 2017, 72, 467–475. [Google Scholar] [CrossRef]
- Sharma, P.; Singh, V.K.; Kumar, G. Synthesis, Antimicrobial Evaluation of Substituted Indole and Nitrobenzenamine based Cr(III), Mn(III) and Fe(III) Metal Complexes. Drug Res. 2021, 71, 455–461. [Google Scholar] [CrossRef]
- Al Zamil, N.O. Synthesis, DFT calculation, DNA-binding, antimicrobial, cytotoxic and molecular docking studies on new complexes VO(II), Fe(III), Co(II), Ni(II) and Cu(II) of pyridine Schiff base ligand. Mater. Res. Express 2020, 7, 065401. [Google Scholar] [CrossRef]
- Nayak, S.G.; Poojary, B. Synthesis of novel Schiff bases containing arylpyrimidines as promising antibacterial agents. Heliyon 2019, 5, e02318. [Google Scholar] [CrossRef]
- Benabid, W.; Ouari, K.; Bendia, S.; Bourzami, R.; Ali, M.A. Crystal structure, spectroscopic studies, DFT calculations, cyclic voltammetry and biological activity of a copper (II) Schiff base complex. J. Mol. Struct. 2020, 1203, 127313. [Google Scholar] [CrossRef]
- Tehrani, K.H.M.E.; Hashemi, M.; Hassan, M.; Kobarfard, F.; Mohebbi, S. Synthesis and antibacterial activity of Schiff bases of 5-substituted isatins. Chin. Chem. Lett. 2016, 27, 221–225. [Google Scholar] [CrossRef]
- El-Faham, A.; Hozzein, W.N.; Wadaan, M.A.M.; Khattab, S.N.; Ghabbour, H.A.; Fun, H.-K.; Siddiqui, M.R. Microwave Synthesis, Characterization, and Antimicrobial Activity of Some Novel Isatin Derivatives. J. Chem. 2015, 2015, 716987. [Google Scholar] [CrossRef]
- Dikio, C.W.; Okoli, B.J.; Mtunzi, F.M. Synthesis of new anti-bacterial agents: Hydrazide Schiff bases of vanadium acetylacetonate complexes. Cogent Chem. 2017, 3, 1336864. [Google Scholar] [CrossRef]
- Al-Hiyari, B.A.; Shakya, A.K.; Naik, R.R.; Bardaweel, S. Microwave-Assisted Synthesis of Schiff Bases of Isoniazid and Evaluation of Their Anti-Proliferative and Antibacterial Activities. Molbank 2021, 2021, M1189. [Google Scholar] [CrossRef]
- Fonkui, T.Y.; Ikhile, M.I.; Njobeh, P.B.; Ndinteh, D.T. Benzimidazole Schif base derivatives: Synthesis, characterization and antimicrobial activity. BMC Chem. 2019, 13, 127. [Google Scholar] [CrossRef]
- Alterhoni, E.; Tavman, A.; Hacioglu, M.; Sahin, O.; Tan, A.S.B. Synthesis, structural characterization and antimicrobial activity of Schiff bases and benzimidazole derivatives and their complexes with CoCl2, PdCl2, CuCl2 and ZnCl2. J. Molec. Struct. 2021, 1229, 129498. [Google Scholar] [CrossRef]
- Kais, R.; Adnan, S. Synthesis, Identification and Studying Biological Activity of Some Heterocyclic Derivatives from 3, 5-Dinitrosalicylic Acid. IOP Conf. Ser. J. Phys. Conf. Ser. 2019, 1234, 01209. [Google Scholar] [CrossRef]
- Govindarao, K.; Srinivasan, N.; Suresh, R. Synthesis, Characterization and Antimicrobial Evaluation of Novel Schiff Bases of Aryl Amines Based 2-Azetidinones and 4-Thiazolidinones. Res. J. Pharm. Technol. 2020, 13, 168–172. [Google Scholar] [CrossRef]
- Mohanty, P.; Behera, S.; Behura, R.; Shubhadarshinee, L.; Mohapatra, P.; Barick, A.K.; Jali, B.R. Antibacterial Activity of Thiazole and its Derivatives: A Review. Biointerface Res. Appl. Chem. 2022, 12, 2171–2195. [Google Scholar]
- Zhu, J.; Teng, G.; Li, D.; Hou, R.; Xia, Y. Synthesis and antibacterial activity of novel Schiff bases of thiosemicarbazone derivatives with adamantane moiety. Med. Chem. Res. 2021, 30, 1534–1540. [Google Scholar] [CrossRef]
- Yakan, H. Preparation, structure elucidation, and antioxidant activity of new bis(thiosemicarbazone) derivatives. Turk. J. Chem. 2020, 44, 1085–1099. [Google Scholar] [CrossRef]
- Vimala Joice, M.; Metilda, P. Synthesis, characterization and biological applications of curcumin-lysine based Schiff base and its metal complexes. J. Coord. Chem. 2021, 74, 2395–2406. [Google Scholar] [CrossRef]
- Omidi, S.; Kakanejadifard, A. A review on biological activities of Schiff base, hydrazone, and oxime derivatives of curcumin. RSC Adv. 2020, 10, 30186–30202. [Google Scholar] [CrossRef]
- Sundriyal, S.; Sharma, R.K.; Jain, R. Current advances in antifungal targets and drug development. Curr. Med. Chem. 2006, 13, 1321–1335. [Google Scholar] [CrossRef]
- Enoch, D.A.; Yang, H.; Aliyu, S.H.; Micallef, C. Human Fungal Pathogen Identification; Springer: New York, NY, USA, 2017; Volume 1508. [Google Scholar]
- Allen, D.; Wilson, D.; Drew, R.; Perfect, J. Azole Antifungals: 35 Years of Invasive Fungal Infection Management. Expert Rev. Anti-Infect. Ther. 2015, 13, 787–798. [Google Scholar] [CrossRef]
- Ejidike, I. Cu(II) Complexes of 4-[(1E)-N-{2-[(Z)-Benzylidene-amino]ethyl}ethanimidoyl]benzene-1,3-diol Schiff base: Synthesis, spectroscopic, in-vitro antioxidant, antifungal and antibacterial studies. Molecules 2018, 23, 1581. [Google Scholar] [CrossRef]
- Li, Z.; Liu, N.; Tu, J.; Ji, C.; Han, G.; Sheng, C. Discovery of Simplified Sampangine Derivatives with Potent Antifungal Activities against Cryptococcal Meningitis. ACS Infect. Dis. 2019, 5, 1376–1384. [Google Scholar] [CrossRef]
- Shafiei, M.; Toreyhi, H.; Firoozpour, L.; Akbarzadeh, T.; Amini, M.; Hosseinzadeh, E.; Hashemzadeh, M.; Peyton, L.; Lotfali, E.; Foroumad, A. Design, Synthesis, and In Vitro and In Vivo Evaluation of Novel Fluconazole-Based Compounds with Promising Antifungal Activities. ACS Omega 2021, 6, 24981–25001. [Google Scholar] [CrossRef]
- Su, H.; Han, L.; Huang, X. Potential Targets for the Development of New Antifungal Drugs. J. Antibiot. 2018, 71, 978–991. [Google Scholar] [CrossRef]
- Montoya, M.C.; Didone, L.; Heier, R.F.; Meyers, M.J.; Krysan, D.J. Antifungal Phenothiazines: Optimization, Characterization of Mechanism, and Modulation of Neuroreceptor Activity. ACS Infect. Dis. 2018, 4, 499–507. [Google Scholar] [CrossRef]
- Malik, M.A.; Lone, S.A.; Gull, P.; Dar, O.A.; Wani, M.Y.; Ahmad, A.; Hashmi, A.A. Efficacy of Novel Schiff base Derivatives as Antifungal Compounds in Combination with Approved Drugs Against Candida Albicans. Med. Chem. 2019, 15, 648–658. [Google Scholar] [CrossRef]
- Wei, L.; Tan, W.; Zhang, J.; Mi, Y.; Dong, F.; Li, Q.; Guo, Z. Synthesis, Characterization, and Antifungal Activity of Schiff Bases of Inulin Bearing Pyridine ring. Polymers 2019, 11, 371. [Google Scholar] [CrossRef]
- Pahontu, E.; Julea, F.; Rosu, T.; Purcarea, V.; Chumakov, Y.; Petrenco, P.; Gulea, A. Antibacterial, antifungal and in vitro antileukaemia activity of metal complexes with thiosemicarbazones. J. Cell. Mol. Med. 2015, 19, 865–878. [Google Scholar] [CrossRef]
- Boros, E.; Dyson, P.J.; Gasser, G. Classification of Metal-based Drugs According to Their Mechanisms of Action. Chem 2020, 6, 41–60. [Google Scholar] [CrossRef]
- Morrison, C.N.; Prosser, K.E.; Stokes, R.W.; Cordes, A.; Metzler-Nolte, N.; Cohen, S.M. Expanding medicinal chemistry into 3D space: Metallofragments as 3D scaffolds for fragment-based drug discovery. Chem. Sci. 2020, 11, 1216–1225. [Google Scholar] [CrossRef]
- Frei, A.; King, A.P.; Lowe, G.J.; Cain, A.K.; Short, F.L.; Dinh, H.; Elliott, A.G.; Zuegg, J.; Wilson, J.J.; Blaskovich, M.A.T. Nontoxic Cobalt(III) Schiff Base Complexes with Broad-Spectrum Antifungal Activity. Chem. Eur. J. 2021, 27, 2021–2029. [Google Scholar] [CrossRef]
- Lin, Y.; Betts, H.; Keller, S.; Cariou, K.; Gasser, G. Recent developments of metal-based compounds against fungal pathogens. Chem. Soc. Rev. 2021, 50, 10346–10402. [Google Scholar] [CrossRef]
- Gehad, G.; Mohamed, M.M.; Omar, M.; Yasmin, M. Metal complexes of Tridentate Schiff base: Synthesis, Characterization, Biological Activity and Molecular Docking Studies with COVID-19 Protein Receptor. J. Inorg. Gen Chem. Z. Anorg. Allg. Chem. 2021, 647, 2201–2218. [Google Scholar]
- Devi, J.; Kumar, S.; Kumar, B.; Asija, S.; Kumar, A. Synthesis, structural analysis, in vitro antioxidant, antimicrobial activity and molecular docking studies of transition metal complexes derived from Schiff base ligands of 4-(benzyloxy)-2-hydroxybenzaldehyde. Res. Chem. Intermed. 2022, 48, 1541–1576. [Google Scholar] [CrossRef]
- Uddin, M.N.; Ahmed, S.S.; Alam, S.M.R. REVIEW: Biomedical applications of Schiff base metal complexes. J. Coord. Chem. 2020, 73, 3109–3149. [Google Scholar] [CrossRef]
- Borase, J.N.; Mahale, R.G.; Rajput, S.S.; Shirsath, D.S. Design, synthesis and biological evaluation of heterocyclic methyl substituted pyridine Schiff base transition metal complexes. SN Appl. Sci. 2021, 3, 197. [Google Scholar] [CrossRef]
- Inan, A.; Ikiz, M.; Tayhan, S.E.; Bilgin, S.; Genç, N.; Sayın, K.; Ceyhan, G.; Kose, M.; Dag, A.; Ispir, E. Antiproliferative, antioxidant, computational and electrochemical studies of new azo-containing Schiff base ruthenium (II) complexes. New J. Chem. 2018, 42, 2952–2963. [Google Scholar] [CrossRef]
- Kizilkaya, H.; Dag, B.; Aral, T.; Genc, N.; Erenler, R. Synthesis, characterization, and antioxidant activity of heterocyclic Schiff bases. J. Chin. Chem. Soc. 2020, 67, 1696–1701. [Google Scholar] [CrossRef]
- Devi, J.; Pachwania, S. Synthesis, characterization, in vitro antioxidant and antimicrobial activities of diorganotin(IV) complexes derived from hydrazide Schiff base ligands. Phosphorus Sulfur Silicon Relat. Elem. 2021, 12, 1049–1060. [Google Scholar] [CrossRef]
- Aidi, M.; Keypour, H.; Shooshtari, A.; Mahmoudabadi, M.; Bayat, M.; Ahmadvand, Z.; Karamian, R.; Asadbergy, M.; Tavatli, S.; Gable, R.W. Synthesis of two new symmetrical macroacyclic Schiff base ligands containing homopiperazine moiety and their mononuclear complexes: Spectral characterization, X-ray crystal structural, antibacterial activities, antioxidant effects and theoretical studies. Polyhedron 2019, 167, 93–102. [Google Scholar] [CrossRef]
- Deswal, S.; Vashistha, V.K.; Kumara, A.; Singha, R. Synthesis, Electrochemical and Antimicrobial Studies of Me6-Dibenzotetraazamacrocyclic Complexes of Ni(II) and Cu(II) Metal Ions. Russ. J. Electrochem. 2019, 55, 161–167. [Google Scholar]
- Singh, B.K.; Mishra, P.; Prakash, A.; Bhojak, N. Spectroscopic, electrochemical and biological studies of the metal complexes of the Schiff base derived from pyrrole-2-carbaldehyde and ethylenediamine. Arab. J. Chem. 2017, 10, S472–S483. [Google Scholar] [CrossRef]
- Sonmez, M.; Hacıyusufoglu, M.E.; Levent, A.; Zengin, H.; Zengin, G. Synthesis of pyrimidine Schiff base transition metal complexes: Characterization, spectral and electrochemical analyses, and photoluminescence properties. Res. Chem. Intermed. 2018, 44, 5531–5554. [Google Scholar] [CrossRef]
- Tsantis, S.T.; Tzimopoulos, D.I.; Holynska, M.; Perlepes, S.P. Oligonuclear Actinoid Complexes with Schiff Bases as Ligands—Older Achievements and Recent Progress. Int. J. Mol. Sci. 2020, 21, 555. [Google Scholar] [CrossRef] [PubMed]
- Yao, Y.; Yin, H.Y.; Ning, Y.; Wang, J.; Meng, Y.S.; Huang, X.; Zhang, W.; Kang, L.; Zhang, J.L. Strong Fluorescent Lanthanide Salen Complexes: Photophysical Properties, Excited-State Dynamics, and Bioimaging. Inorg. Chem. 2019, 58, 1806–1814. [Google Scholar] [CrossRef] [PubMed]
- Andrez, J.; Guidal, V.; Scopelliti, R.; Pécaut, J.; Gambarelli, S.; Mazzanti, M. Ligand and Metal Based Multielectron Redox Chemistry of Cobalt Supported by Tetradentate Schiff Bases. J. Am. Chem. Soc. 2017, 139, 8628–8638. [Google Scholar] [CrossRef]
- Balas, M.; KBidi, L.; Launay, F.; Villanneau, R. Chromium-Salophen as a Soluble or Silica-Supported Co-Catalyst for the Fixation of CO2 Onto Styrene Oxide at Low Temperatures. Front. Chem. 2021, 9, 765108. [Google Scholar] [CrossRef] [PubMed]
- North, M.; Quek, S.C.Z.; Pridmore, N.E.; Whitwood, A.C.; Wu, X. Aluminum(salen) Complexes as catalysts for the Kinetic Resolution of Terminal Epoxides via CO2 Coupling. ACS Catal. 2015, 5, 3398–3402. [Google Scholar] [CrossRef]
- Castro-Osma, J.A.; Lamb, K.J.; North, M. Cr(salophen) Complex Catalyzed Cyclic Carbonate Synthesis at Ambient Temperature and Pressure. ACS Catal. 2016, 6, 5012–5025. [Google Scholar] [CrossRef]
- Tuna, M.; Tuğba Uğur, T. Investigation of The Effects of Diaminopyridine and o-Vanillin Derivative Schiff Base Complexes of Mn(II), Mn(III), Co(II) and Zn(II) Metals on The Oxidative Bleaching Performance of H2O2. SAUJS 2021, 25, 984–994. [Google Scholar]
- Bulduruna, K.; Özdemir, M. Ruthenium(II) complexes with pyridine-based Schiff base ligands: Synthesis, structural characterization and catalytic hydrogenation of ketones. J. Mol. Struct. 2020, 1202, 127266. [Google Scholar] [CrossRef]
- Shaw, S.; White, J.D. Asymmetric Catalysis Using Chiral Salen–Metal Complexes: Recent Advances. Chem. Rev. 2019, 119, 9381–9426. [Google Scholar] [CrossRef]
- Cozzi, P.G. Metal-salen Schiff base complexes in catalysis: Practical aspects. Chem. Soc. Rev. 2004, 33, 410–421. [Google Scholar] [CrossRef] [PubMed]
- Racles, C.; Zaltariov, M.F.; Iacob, M.; Silion, M.; Avadanei, M.; Bargan, A. Siloxane-based metal–organic frameworks with re markable catalytic activity in mild environmental photodegradation of azo dyes. Appl. Catal. B Environ. 2017, 205, 78–92. [Google Scholar] [CrossRef]
- Maharana, T.; Nath, N.; Pradhan, H.C.; Mantri, S.; Routaray, A.; Sutar, A.K. Polymer-supported first-row transition metal schiff base complexes: Efficient catalysts for epoxidation of alkenes. React. Funct. Polym. 2022, 171, 105142. [Google Scholar] [CrossRef]

Publisher’s Note: MDPI stays neutral with regard to jurisdictional claims in published maps and institutional affiliations. |
© 2022 by the authors. Licensee MDPI, Basel, Switzerland. This article is an open access article distributed under the terms and conditions of the Creative Commons Attribution (CC BY) license (https://creativecommons.org/licenses/by/4.0/).
Share and Cite
Soroceanu, A.; Bargan, A. Advanced and Biomedical Applications of Schiff-Base Ligands and Their Metal Complexes: A Review. Crystals 2022, 12, 1436. https://doi.org/10.3390/cryst12101436
Soroceanu A, Bargan A. Advanced and Biomedical Applications of Schiff-Base Ligands and Their Metal Complexes: A Review. Crystals. 2022; 12(10):1436. https://doi.org/10.3390/cryst12101436
Chicago/Turabian StyleSoroceanu, Alina, and Alexandra Bargan. 2022. "Advanced and Biomedical Applications of Schiff-Base Ligands and Their Metal Complexes: A Review" Crystals 12, no. 10: 1436. https://doi.org/10.3390/cryst12101436
APA StyleSoroceanu, A., & Bargan, A. (2022). Advanced and Biomedical Applications of Schiff-Base Ligands and Their Metal Complexes: A Review. Crystals, 12(10), 1436. https://doi.org/10.3390/cryst12101436

